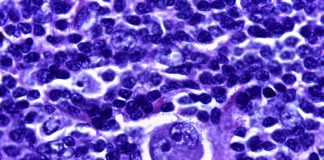
Cum se manifesta Limfomul Hodgkin sau cancerul sistemului limfatic
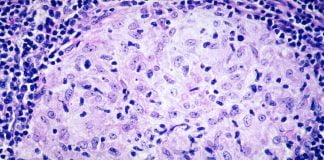
Granulomul inghinal sau donovanoza, o boala deosebit de contagioasa

Hemangioamele – Tumori vasculare de tip benign
Cele mai frecvente tumori ale copilariei sunt hemangioamele, ele reprezinta 50% din totalul tumorilor de piele la copiii care au varsta pana in 10...
Cum se manifesta Limfomul Hodgkin sau cancerul sistemului limfatic?
Limfomul Hodgkin sau cancerul la sistemul limfatic este o boala a carei cauza inca nu s-a determinat foarte exact pana in prezent. Cercetatorii au...
Granulomul inghinal sau donovanoza, o boala deosebit de contagioasa
Una din bolile genitale sau infectiile cronice bacteriene ale regiunii genitale care se transmite in special prin contact sexual este granulomul inghinal sau altfel...
Ce sunt infectiile stafilococice si cum se transmit?
In ultimii anii infectiile stafilococice sunt cele mai frecvente, ele apar la un numar din ce in ce mai mare de pacienti datorita prezentei...
Cheaguri de sange – Cauze si metode de tratament
In functie de locurile unde apar in organism dar si de marimea lor, aceste cheaguri de sange anormale pot fi mai mult sau mai...
Cum putem trata singuri durerile de spate?
Durerile de spate pot sa apara in mod surprinzator si pot fi cauzate de obicei de alte boli. Acestea sunt foarte frecvente si au...
Litiaza biliara – Metode de tratament naturiste
Exista o serie de metode de tratament naturiste pentru litiaza biliara. Dupa cum se stie calculii biliari ce apar in tractul biliar pot avea...
Cum tratam ulcerul gastroduodenal?
Una din bolile cele mai grave care a ,,chinuit” populatia globului este ulcerul gastroduodenal. Cei care sufera de aceasta boala si in general de...
Leziunea herpetica, metode de tratament
Leziunea herpetica este o boala virala cauzata de virusul herpes simplex (numit simplu HSV) si care se manifesta prin basicute umflate si pline cu...
Metode de tratament pentru fisura anala
Fisura anala este o afectiune care apare destul de des ca rezultat al bolilor colonului, a hemoroizilor, constipatiei cronice, accidentarilor anusului, tulburarilor circulatorii ale...
Ce trebuie sa facem cand avem crampe la picioare?
Aceasta afectiune – crampe la picioare – apare mai ales cand stam in apa rece, de exemplu cand facem o baie la piscina sau...
Cum se trateaza fasceita plantara sau durerea la calcai?
Fasceita plantara este o afectiune ce provoaca durere la calcai deoarece reprezinta inflamarea ligamentului care face legatura dintre calcai si degete si care poarta...
Cancer la gat, tratament prin radiochirurgia CyberKnife
Cancerul la gat sau cancerul laringian se poate trata prin intermediul unui sistem foarte eficient numit radiochirurgia CyberKnife. Acest echipament ultra-modern are capacitatea de...
Balbismul sau balbaiala, o afectiune intalnita des la copii
Balbaiala este o afectiune cunoscuta si cu denumirea stiintifica de logonevroza sau balbaiala. Pentru a o intelege mai bine medicii spun simplu ca balbaiala...
Cum apare cancerul? Metode de tratament naturiste
Cum apare cancerul? Exista cateva semne clare ce ne pot ingrijora de aparitia acestei boli ingrozitoare. Conform medicilor cancerul este o boala grava care...